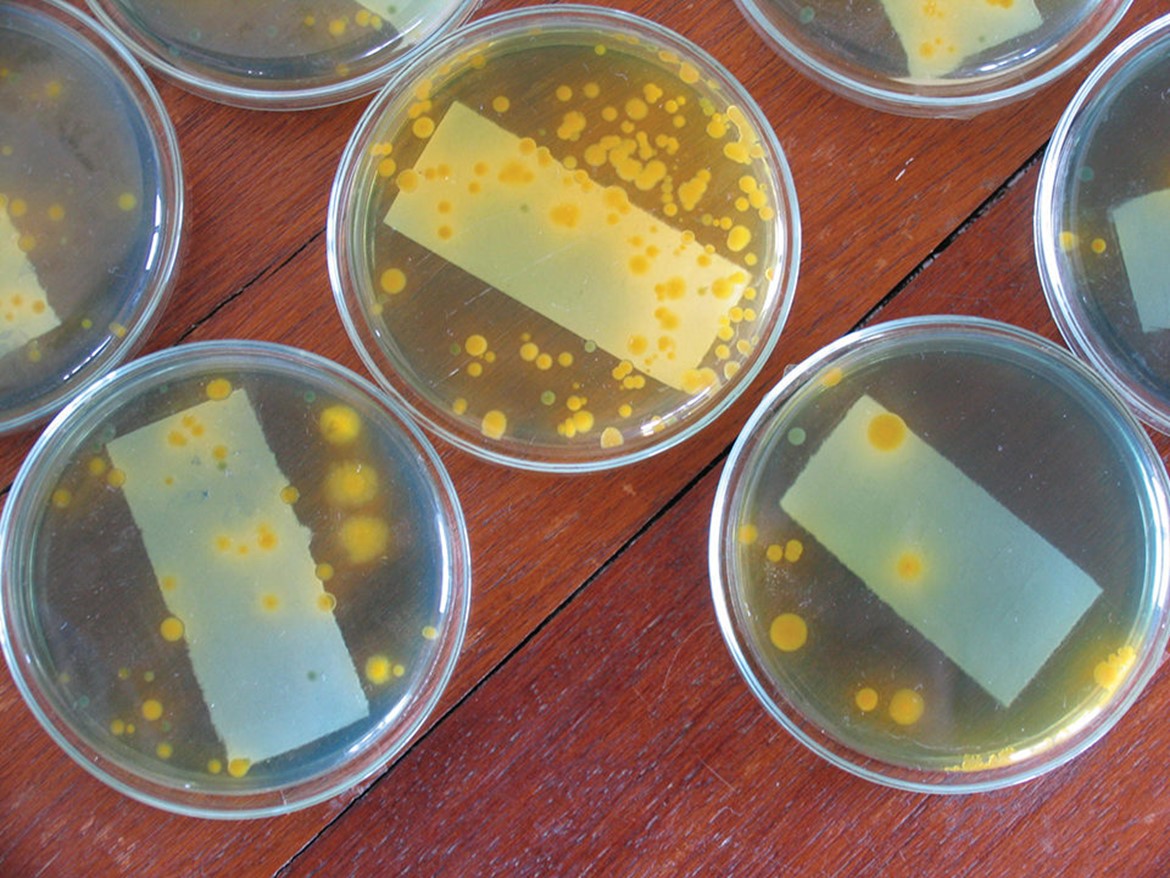

Understanding the role of antibiotics in aquaculture production

Annual global aquaculture production has more than tripled in recent years, and by 2015, close to half of seafood production by weight will be obtained from aquaculture. Increased food production through aquaculture is an exciting opportunity. However, as aquaculture output continues to rise, some aquaculture facilities depend on antibiotics, which with continued use provide an opportunity to lead to antibiotic-resistant bacteria and elevated antibiotic residues. Populations at risk of exposure to antibiotics include individuals employed in aquaculture facilities, populations living close to aquaculture facilities and consumers of aquaculture food products.
Antibiotics in aquaculture
Antibiotics are a group of natural or synthetic compounds that kill or limit the ability of bacteria to grow. Under the conditions in which some animals are raised, the risk of bacterial infection is high and has significant economic consequences. Therefore, antibiotics are administered to fish and shellfish for therapeutic and/or prophylactic purposes.
Many countries lack regulations on the types and amounts of antibiotics that can be administered to aquaculture animals. The problem becomes more critical when farmers and workers lack adequate information on the safe and effective use of antibiotics, which can result in excessive usage.
Some countries have comprehensive regulations on antibiotics that include what antibiotics can be administered to specific fish or shellfish species, the maximum dosages that can be administered over time, and the withdrawal times required before the animals can be introduced into the market for human consumption. Table 1 shows the antibiotics listed by the Food and Agriculture Organization as potentially used in aquaculture facilities.

Estimates from some European countries show that the amounts of antimicrobials used per ton of aquaculture products vary from 2 g in Norway to 40 to 100 g in Denmark, France and Greece. Outside the European Union, per-ton figures as high as 700 g have been recorded.
No antimicrobial agent has ever been developed specifically for aquaculture applications. The antibiotics used in aquaculture have been developed for and are used to treat humans or land-based animals. Both in the European Union and the United States, antibiotics are approved solely to treat diseases as labeled and cannot be used prophylactically or for growth promotion in aquaculture. Antibiotics are incorporated into medicated feeds and never added to culture water to treat bacterial diseases.
Antibiotic-resistant bacteria
Several studies have shown elevated levels of bacterial antibiotic resistance in and adjacent to aquaculture production facilities. The transfer of antibiotic-resistant genes and selection for resistant bacteria can occur through a variety of mechanisms, which may not always be linked to specific antibiotic use. Resistance arises and is maintained through mutations in bacterial DNA or through horizontal gene transfer mechanisms, including conjugation with other bacteria, transduction bacteriophages and the uptake of free DNA via transformation.
A study of Gram-negative bacteria – predominately Plesiomonas shigelloides and Aeromonas hydrophila – from aquaculture ponds in the southeastern United States reported that the proportion of bacteria resistance to tetracycline, oxytetracycline, chloramphenicol, ampicillin and nitrofurantoin was higher in fish in antibiotic-treated ponds than in those in untreated waters. A study in the Philippines reported that the prevalence of multiple antibiotic resistance was highest in shrimp where oxolinic acid was administered, versus ponds where no antibiotics were used.
Researchers in Malaysia who isolated Aeromonas bacteria from fish tissue determined that all isolates were resistant to three or more antibiotics tested in the study. In Japan, tetracycline-resistant bacteria were obtained from three fish farms. The resistance genes carried in the fish isolates exhibited high sequence similarities with tetracycline resistance genes in human clinical isolates. Another study in Japan demonstrated the presence of beta-lactamase resistance genes in Stenotrophomonas maltophilia isolated from farmed yellowtail fish was likely the result of horizontal gene transfer events.
Antibiotic residues
Treating fish with antibiotics can result in antibiotic residues in ponds, sediments, aquaculture products and wild aquatic organisms in proximity to the treated ponds. Some shrimp ponds in Vietnam were found to contain elevated residues of trimethoprim, sulfamethoxazole, norfloxacin and oxolinic acid in water and sediment samples.
A study in Norway showed that wild fish and shellfish near ponds whose animals received medicated feed contained elevated concentrations of oxolinic acid in their plasma, livers and muscle tissue. Antibiotic residues in the environment present additional problems, not all of which have been completed defined. Many antibiotics are toxic to aquatic organisms, including daphnia and Artemia.
Human concerns
Antibiotic-resistant bacteria can cause infections in humans through consumption of contaminated aquaculture food products or through drinking water, and by direct contact with water, aquatic organisms or aquaculture food products. The 2008 European Commission Rapid Alert System for Food and Feed report said that 59 percent of the notifications of residues of veterinary medical products were associated with crustaceans (55 percent involving chloramphenicol and nitrofurantoin) and fish (4 percent malachite green).
Since most fish pathogens are incapable of growing at human and terrestrial animal body temperatures, the risk of transmission of pathogens from fish or shellfish to humans is fairly small. However, the effects of antibiotic residues on chronic human health have not been defined.
While many employees in aquaculture facilities are exposed to only minimal quantities of antibiotics, some work with antibiotics on a daily basis. Consequently, a lack of protective equipment may contribute to a significant health risk through inhalation as well as dermal exposures through exposed or injured skin.
This is of significant concern, especially when environmental exposure to antibiotics such as chloramphenicol, a potential human carcinogen, may have been related to an increased risk of aplastic anemia and leukemia in humans. The health risks of low levels of antibiotic exposure have not been adequately studied.
In order to fully understand and prevent the health risks presented by antibiotic use in aquaculture, researchers, governments and the aquaculture industry must work cooperatively to identify what problems exist and develop solutions that are achievable, effective and enforceable.
By George J. Flick, David D. Kuhn
Source: https://www.globalseafood.org/advocate/antibiotic-resistant-bacteria-part-1/
Read more:
- Effective antioxidant and antimicrobial feed additives for juvenile Pacific white shrimp farmed at high density
- Common salt a useful tool in aquaculture, part 1
- Good Shrimp, Bad Shrimp: How Shrimp Farming Practices Impact The Environment. (Part 1)